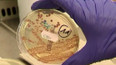
Věda online

16. května 2021
Obsah dílu
Koronavirus: kolektivní imunita — Satelity Copernicus jako pomocníci alergiků — Na Marsu přistála čínská sonda — Věda ve světě stručně — OSN se chce zaměřit na emise metanu — Hyde Park Civilizace: Charles Rice — Protilátky na klíšťovou encefalitidu — Věda online — Věda kolem nás: jak funguje lednice — Model krakatice obrovské — Medaile za zásluhy pro tým Vědy 24
Části dílu

Přehled dílů

21. prosince 2025
NASA má nového administrátora — Evropa míří k zákazu tzv. věčných chemikálií — Výskyt lepry v Evropě — Teplotní inverze v Česku — 10 let od úspěšného přistání nosné rakety Falcon 9 — Začíná astronomická zima — Věda online — Hyde Par Civilizace v roce 2025 — Nový systém na pomoc záchranářům a armádě — Věda kolem nás: kypřicí prášek do těsta — Statistika ohledně vánočních stromků a rychlost pohybu Ježíška

14. prosince 2025
Přibývá satelitů a komplikuje to vesmírná pozorování — Česko je na prahu chřipkové epidemie — Málo státních peněz na českou vědu — Kočka divoká se vrací do české krajiny — Předávání Nobelových cen, oceněni byli i tvůrci AI — Lidé ovládli oheň o 350 000 let dřív, než se předpokládalo — Věda online — Počasí na Vánoce — Hyde Park Civilizace: Karl Bushby – pěšky kolem světa — Věda kolem nás: časy východů a západů Slunce — Chobotnice hrající na piano

7. prosince 2025
NASA našla cukry ve vzorcích z asteroidu Benu — Americká léková agentura chce zpřísnit schvalování vakcín — Vědci z AV ČR popsali proces, jak probíhá první fáze infekce lymské boreliózy — Vědci v praxi ověřili, jak mohl vypadat pravěký lov — Konference Quantum Day 2025 zaměřující se na využití kvantových technologií — Věda online — Hyde Park Civilizace: sociální psycholožka Iva Poláčková Šolcová — Výzkum přírody na antarktickém ostrově Jamese Rosse — Olympijská pochodeň — Zákony robotiky Isaaca Asimova — Věda kolem nás: mikrovlnná trouba — Adventní kalendář vánočních zajímavostí

30. listopadu 2025
Mozkový implantát testuje další firma — Žloutenka typu A se v Česku dál šíří — Se šířením virů a bakterií pomáhají desinfekční prostředky — Otazník nad dalšími ruskými pilotovanými lety do kosmu — S obnovou korálových útesů by mohla pomoct AI — Agrese mezi dětmi v online prostoru narůstá — Jedna z největších zelených stěn v Evropě vznikla nedaleko Prahy — Robotický skener slouží v Kriminalistickém ústavu PČR — Věda online — Před 110 Albert Einstein představil obecnou teorii relativity — Hyde Park Civilizace: Susumu Tonegawa — Věda kolem nás: beton — Pustí lidé v metru sednout těhotnou ženu, nebo Batmana?

23. listopadu 2025
Požár a protesty na konferenci COP30 — Častá konzumace ultrazpracovaných jídel může poškodit zdraví — Čeští vědci objevili nového prvoka — Lidé, kteří se učí nové jazyky, pomaleji stárnou — Hyde Park Civilizace: Tomáš Cihlář — Vyjádření k údajnému vztahu vakcín a autismu — Úspěch studentů z Masarykovy univerzity a Vysokého učení technického — Projekt Otevřená věda Akademie věd ČR — Věda online — 80 let od začátku norimberského procesu — Věda kolem nás: vysílání České televize — Šimpanzi se umí rozhodovat podobně jako lidé

16. listopadu 2025
Nanomateriály mění svět — Předvečer 17. 11. 1989 — Hyde Park Civilizace: listopad 1989 pohledem Václava Malého — Druhý start obří rakety New Glenn — Ceny Technologické agentury ČR — Jak Češi používají internet a AI — Výprava k objasnění původu eukaryotické buňky — Polární záře v Česku — Věda online — Nová interaktivní výstava ESA Země z vesmíru — Satelitní snímky Země jako zdroj zábavy — Věda kolem nás: technický sníh — Taktika drobných pavouků v obraně proti predátorům

9. listopadu 2025
Tři čtvrtě miliardy pro projekty českých vědců — Co nabízí Velké egyptské muzeum — Zemřel polární klimatolog Pavel Prošek — Projekt Hejbni vědou na podporu výzkumu vzácných nemocí — Týden Akademie věd ČR — V Amazonii startuje klimatický summit COP30 — Věda online — Hyde Park Civilizace: — Věda kolem nás: rentgenové záření — Pravděpodobně největší pavučina na světě

2. listopadu 2025
Věda kolem hurikánu Melissa — 28. říjen pohledem vědecké redakce — Jak poznat videa vygenerovaná AI — Nový rektor Univerzity Karlovy — Výzkumy oceněné Akademickou prémií — Festival Týden Akademie věd ČR — Věda online — Hyde Park Civilizace: Milan Trojánek – nadužívání antibiotik — Věda kolem nás: jak vznikají perly — ISS je už 25 let trvale obydlená

26. října 2025
České experimenty na ISS — Volba rektorů tří českých vysokých škol — Nadváha a obezita u mladistvých — Nové české vysokofrekvenční EKG — Snaha AI se zavděčit může ohrozit lidské zdraví nebo život — Hyde Park Civilizace: Paul Milgrom — Věda online — Nový výzkum slibuje přesnější určení životnosti baterií do elektromobilů — Úspěch výstavy Lucy a Selam — Nová kniha Planeta tajícího ledu — Věda kolem nás: dlouhověkost u velryb — Nejdelší tvor světa – medúza talířovka obrovská

19. října 2025
Nový seznam ohrožených druhů — Česko má kvantovou strategii — Kompletní znění dopisu prezidenta Masaryka — Úroveň oxidu uhličitého v atmosféře vzrostla na nová maxima — Ekonomické dopady klimatické změny — Nejdelší dinosauří trasa objevená v Evropě — Náhlá srdeční smrt — Nový lék na Huntingtonovu nemoc — Věda online — Hyde Park Civilizace: studium háďátka obecného – Victor Ambros — Věda kolem nás: jak funguje lidská paměť — Soutěž Nikon Small World



